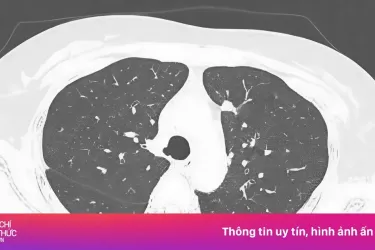

Sản phẩm chăm sóc da có tốt đến mấy, từ thương hiệu uy tín đến đâu nhưng nếu bạn mua phải hàng giả thì chẳng những không thể chăm da khỏe đẹp mà còn tiền mất, tật mang.
Ceramides: Lipid quan trọng tạo hàng rào bảo vệ da khỏe - đẹp
Nghe nhiều về Ceramides nhưng liệu bạn đã thực sự biết Ceramides là gì? Ceramides là acid béo chiếm đến 50% lipid ở lớp ngoài cùng của da, đóng vai trò như "chất keo" liên kết tế bào, giúp củng cố hàng rào bảo vệ da và giữ ẩm hiệu quả. Nhờ đó, da khỏe mạnh hơn và hạn chế các vấn đề như mụn, chàm, vẩy nến hay viêm da cơ địa. Tuy nhiên, lượng Ceramides tự nhiên trong da có thể suy giảm do lão hóa, ánh nắng và các yếu tố môi trường. Vì vậy, bổ sung Ceramides là cần thiết để duy trì làn da ẩm mịn, khỏe đẹp và chống lại các hư tổn.
CeraVe: Phát triển bởi chuyên gia từ khoa học làn da
CeraVe với lịch sử thương hiệu 20 năm, là nhãn hiệu chăm sóc da số 1 tại Mỹ (*), được nghiên cứu phát triển bởi các chuyên gia da liễu.
Xuất thân từ những chuyên gia da liễu với sự thấu hiểu khoa học làn da, CeraVe từ buổi đầu hình thành đã lấy Ceramides làm yếu tố then chốt để phát triển các dòng sản phẩm của mình. Cùng công nghệ độc quyền MVE, ứng dụng vào các sản phẩm của mình. Nói đến CeraVe là nói đến công thức chăm sóc kết hợp 3 loại Ceramides thiết yếu 1, 3, 6-II cùng công nghệ độc quyền cấp khóa ẩm 48H.
Danh mục sản phẩm của CeraVe phục vụ đủ nhu cầu chăm sóc da toàn thân từ da mặt đến cơ thể. Từ các dòng sản phẩm Care, Cleanser, Facial Moisturising đến Blemish Control, đều được các chuyên gia đánh giá cao về độ lành tính, khả năng cấp ẩm, khóa ẩm, làm sạch da an toàn.
Dưỡng ẩm với 3 Ceramides thiết yếu, CeraVe đồng hành chăm da khỏe đẹp
Dòng dưỡng ẩm toàn thân với kết cấu mỏng nhẹ, thấm nhanh. Chứa 3 loại Ceramides thiết yếu và Hyaluronic Acid giúp dưỡng ẩm sâu, phục hồi hàng rào bảo vệ da. Công nghệ độc quyền MVE cấp ẩm liên tục suốt 48H. Sản phẩm có 2 dạng kết cấu: sữa và kem, phù hợp cho da thường đến da khô.
Với nhu cầu làm sạch, một sản phẩm làm sạch hiệu quả không chỉ là việc làm sạch da mà còn phải cung cấp đủ độ ẩm sau khi rửa. Sữa rửa mặt CeraVe chứa Niacinamide giúp làm dịu và duy trì độ ẩm tự nhiên của da với Axit Hyaluronic. Và quan trọng nhất, dù là sữa rửa mặt cho da nào cũng luôn có 3 loại Ceramides thiết yếu giúp dưỡng ẩm và phục hồi hàng rào bảo vệ cho da.
Da thường đến dầu: Foaming Cleanser dạng gel tạo bọt giúp làm sạch sâu, thông thoáng lỗ chân lông, kiềm dầu và loại bỏ lớp chống nắng.
Da thường đến khô: Hydrating Cleanser làm sạch dịu nhẹ, đồng thời cấp ẩm, giảm tình trạng khô ráp.
Làm sạch & tẩy trang 2-trong-1: Hydrating Cream-to-Foam Cleanser chứa Amino Acid giúp chuyển dạng kem thành bọt, làm sạch sâu và lớp trang điểm nhưng vẫn giữ ẩm.
Da sần sùi: SA Smoothing Cleanser chứa Salicylic Acid tẩy da chết dịu nhẹ, đồng thời phục hồi hàng rào ẩm.
Dòng dưỡng ẩm da mặt CeraVe giúp phục hồi hàng rào bảo vệ da và dưỡng ẩm sâu đến 10 lớp (**), khóa ẩm suốt 48 giờ nhờ 3 loại Ceramides thiết yếu (1, 3, 6-II) cùng công nghệ MVE độc quyền.
Oil Control Moisturising Gel-Cream: Kiềm dầu lành tính nhờ Niacinamide, Silica và tinh bột bắp; phù hợp da dầu.
PM Facial Moisturising Lotion: Sữa dưỡng ẩm dịu nhẹ với Hyaluronic Acid và Niacinamide, phù hợp da thường.
Sữa dưỡng ẩm ban ngày SPF50: Bảo vệ da khỏi tia UVA/UVB, ô nhiễm và hỗ trợ phục hồi hàng rào bảo vệ da, dùng được cho da thường đến da khô.
Bộ sản phẩm giảm mụn CeraVe hỗ trợ làm sạch - chăm sóc da mụn toàn diện:
Blemish Control Cleanser: Sữa rửa mặt chứa Salicylic Acid và đất sét tinh khiết giúp làm sạch sâu, kiểm soát dầu và giảm mụn, đồng thời cải thiện chức năng hàng rào da với 3 loại Ceramides thiết yếu.
Blemish Control Gel: Gel giảm mụn chứa AHA & BHA giúp giảm trên 40% kích thước nang mụn chỉ sau 3 ngày (***), và không gây khô da.
Resurfacing Retinol Serum: Dưỡng chất dưỡng da, làm da mềm mịn và giúp phục hồi da, giảm thâm mụn và giúp thu nhỏ lỗ chân lông.
CeraVe tự hào là nhãn hàng được phát triển cùng chuyên gia da liễu, tất cả sản phẩm đều chứa 3 loại Ceramides thiết yếu 1, 3, 6-II giúp phục hồi hàng rào bảo vệ da, dưỡng ẩm da dịu nhẹ, an toàn. CeraVe là nhãn hàng chăm sóc da số 1 tại Mỹ được chuyên gia chăm sóc da khuyên dùng (*). Tìm hiểu sản phẩm trước khi sử dụng và tìm mua tại các kênh phân phối chính hãng để không "tiền mất - tật mang".
Tìm hiểu thêm thông tin về sản phẩm tại Facebook và các trang chính thức của khác nhãn hàng
(*) Theo kết quả nghiên cứu của IQVIA sử dụng khảo sát ProVoice được cấp cho các chuyên gia chăm sóc da và ghi lại các khuyến nghị cho 37 danh mục chăm sóc da OTC trong thời gian 12 tháng kết thúc tháng 1.2025
(**) Kết quả thử nghiệm sản phẩm trên 25 người tình nguyện và đo độ ẩm trên da tương đương 10 lớp tế bào biểu bì bằng máy đo Corneometer CM 825
(***) Kết quả thử nghiệm trên 51 người tình nguyện sử dụng sản phẩm sau 3 giờ